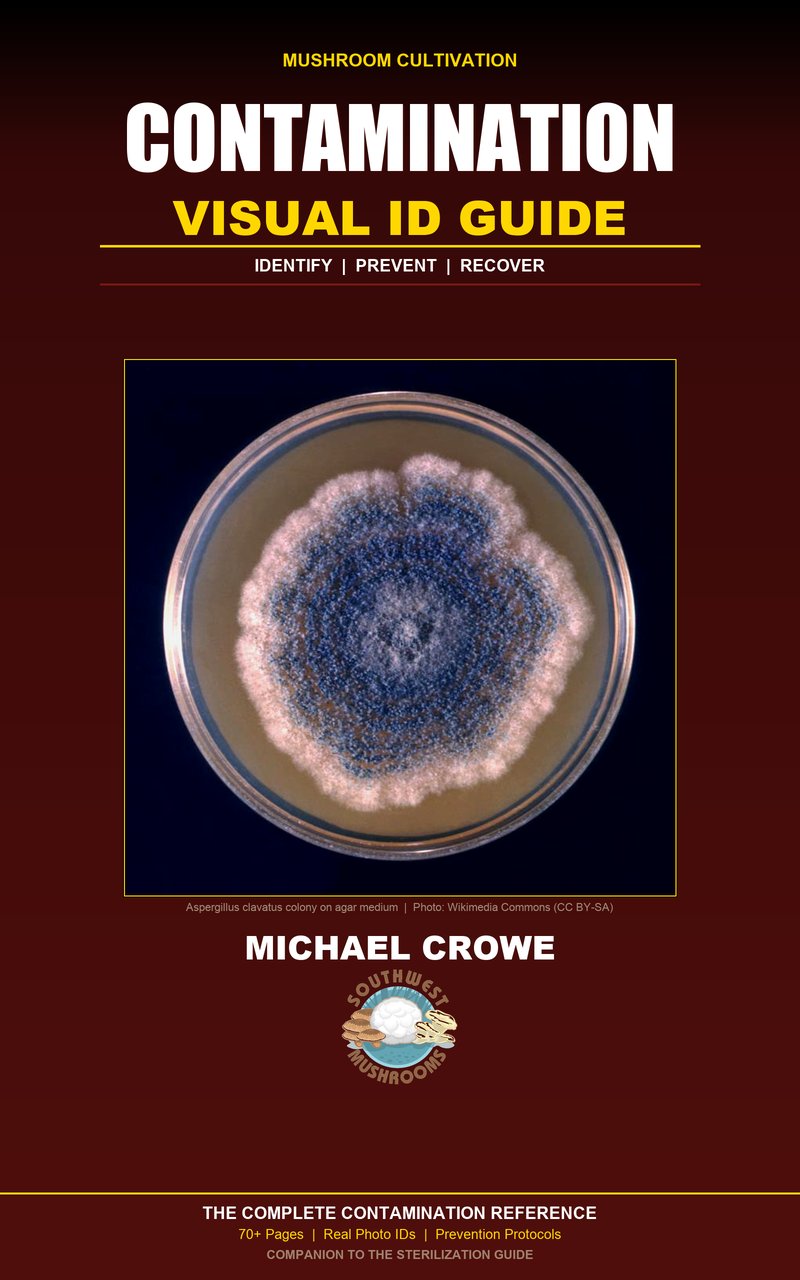
Contamination Visual ID Guide by Michael Crowe

Phoenix-grown since 2017
Grow Better Mushrooms, Faster.
Premium cultures, practical guides, and real-world farm knowledge.
Featured Tinctures
Triple-extracted, 100% fruiting body - from mushrooms we grow ourselves
Discover our full collection: Cordyceps, Turkey Tail, Maitake, and more
Explore All Tinctures
The Mushroom Grower
A Marriage Between Science and Art
Nearly 20 years of hands-on cultivation expertise in one comprehensive guide. 28 chapters, 200+ photos, 30 recipes — from hobby grower to commercial scale.
Southwest Mushrooms Merch
Rep your favorite mycology brand
From Our Farm to Your Shelf
20 years of cultivation knowledge. Instant digital download.

Zero Contamination
Sterilization Guide
The exact sterilization techniques we use at our Phoenix facility. From pressure cookers to commercial-scale atmospheric steam.
Contamination
Visual ID Guide
Identify, prevent, and recover. Real photo IDs, decision flowcharts, and the protocols that dropped contamination from 25% to under 2%.

Business Starter
Blueprint
Turn your grow into a business. Real financial models, marketing playbooks, and year-by-year growth roadmaps from a real farm.
The Brain Mushroom
Lion's Mane
Discover the incredible cognitive benefits and delicate seafood-like flavor of Hericium erinaceus.
Living Mycelium Solutions
Liquid Culture
Explore our premium liquid cultures - the fastest way to inoculate grain spawn with vigorous, clean mycelium.
From Culture to Colonization
Spawn Production
Learn to create high-quality grain spawn that colonizes quickly and produces abundant harvests.
Where the Magic Happens
Fruiting Chamber
Optimal fruiting conditions are key to abundant harvests. Learn to create the perfect environment for your mushrooms.
The Umami King
Shiitake
Rich, earthy, and packed with immune-boosting compounds. A culinary essential for every kitchen.
The Mushroom of Immortality
Reishi
Ancient wisdom meets modern science. Explore the adaptogenic power of Ganoderma lucidum.
From Our Grow Rooms
See where your mushrooms come from - real photos from our Phoenix cultivation facility.







Our Story
Meet Michael Crowe
My mushroom journey began in 2006, growing in a small bedroom at my grandma's house. What started as curiosity has become a lifelong passion. Southwest Mushrooms has grown into a thriving family operation.
Every product we sell comes from real cultivation knowledge - not just theory, but hands-on experience solving the same problems you'll face.
Read Our Full Story




